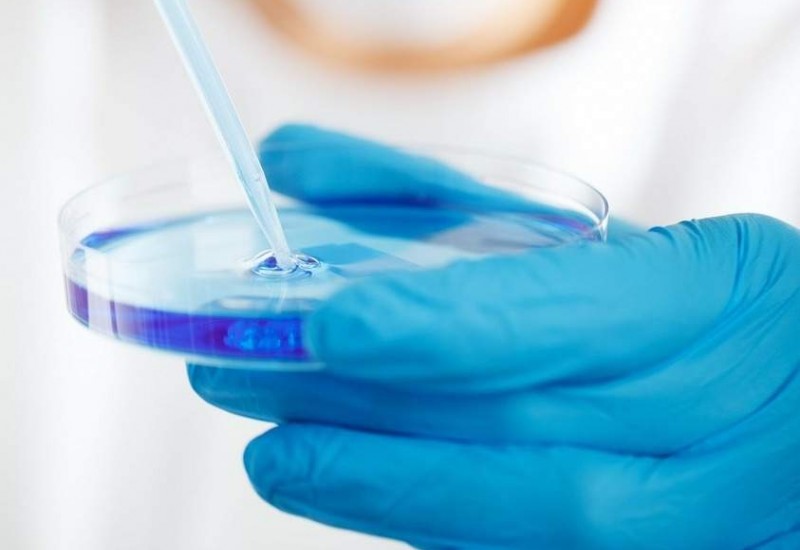
ADCbio

Chemspec highlight: Pharma outsourcing – best practices
“Fail early and fail cheap” – this was the key message from Dr Magid Abou-Gharbia of the Moulder Center for Drug Discovery Research at Temple University’s School of Pharmacy in Philadelphia, US.
Process innovation needs to be undertaken in early R&D phase, predicts ADC Bio
Takeda and Shire settle on US$62 billion deal
After months of discussions, Japan’s Takeda Pharmaceutical Company has reached an agreement to acquire Shire for US$62 billion (see SCM, May, p.20). The acquisition is expected to create a global, R&D-driven biopharmaceutical leader headquartered in Japan and better position Takeda to deliver highly-innovative medicines and transformative care globally. The transaction is expected to close in the first half of 2019.
Madison Dearborn Partners to acquire Alcami
Alcami Corporation, a leading provider of fully-integrated custom end-to-end solutions for the pharmaceutical and biotechnology industries, has reached an agreement to be acquired by Madison Dearborn Partners (MDP), a leading private equity firm based in Chicago. MDP will acquire a majority ownership position in Alcami from existing shareholder Ares Capital Corporation.
The transaction is expected to be completed in the third quarter of 2018, pending customary closing conditions.
DCAT awards scholarships for astonishing student projects
The Drug, Chemical & Associated Technologies Association (DCAT) has announced the winners of four scholarships presented at the Intel International Science & Engineering Fair (Intel ISEF) Special Awards Ceremony on 17 May in Pittsburgh, Pennsylvania.
CPhI: Science fiction and innovation
This year’s InformEx/CPhI North America event was buzzing, with thousands of attendees and over 25 high-profile speakers in a conference programme focused on the latest drug development innovations and manufacturing technologies.
The future of medicines and advances made so far were hot topics at this year’s event, held in Philadelphia on the 24-26 April.